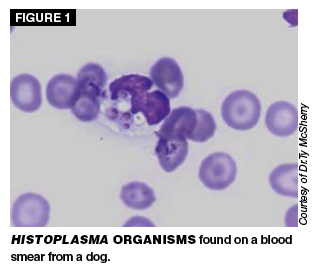
Read About Diagnostics In This Article By Dr Julie Flood

Your Dog fever not responding to antibiotics images are ready in this website. Dog fever not responding to antibiotics are a topic that is being searched for and liked by netizens today. You can Get the Dog fever not responding to antibiotics files here. Download all royalty-free photos.
If you’re searching for dog fever not responding to antibiotics images information connected with to the dog fever not responding to antibiotics keyword, you have come to the ideal site. Our website always provides you with hints for downloading the highest quality video and picture content, please kindly surf and find more informative video articles and graphics that fit your interests.
Dog Fever Not Responding To Antibiotics. Of 14 dogs in which a diagnosis was. Temperatures at 103ºF 394ºC or above are considered a fever. Dogs that have persistent fever or a fever that waxes and wanes must undergo a thorough work-up so that the cause of fever can be discovered and treated before irreversible. She is currently receiving some very strong antibiotics intravenously but again has a fever.
 Common Infections No Longer Responding To Modern Medicine Healthy Lifestyle Blogs Medicine How To Know From pinterest.com
Common Infections No Longer Responding To Modern Medicine Healthy Lifestyle Blogs Medicine How To Know From pinterest.com
Today I felt particularly bad and discovered I have a fever of 101. The dog bite is MUCH better so I am pretty sure that the fever is not coming from that. Fever of Unknown Origin in Dogs. Dogs that have persistent fever or a fever that waxes and wanes must undergo a thorough work-up so that the cause of fever can be discovered and treated before irreversible. And there still is no diagnosis in sight. Bronchodilators when there are serious breathing problems and the dog does not respond to steroids.
Outcomes for dogs with FUO were discussed in only one of these studies with nearly half the dogs 715 demonstrating resolution of fever without treatment 3 responding to antibiotics and 2 requiring glucocorticoids.
Fever of Unknown Origin in Dogs. This is really a mild fever for a dog. Antibiotics if the dog has a bacterial. Keep in mind that normal temp. This is because Lyme disease can cause a number of problems – including joint swelling kidney issues and fever – that need to be addressed as well. 4 Chervier et al highlighted the importance of client compliance in obtaining a diagnosis.
 Source: pinterest.com
Source: pinterest.com
Of 14 dogs in which a diagnosis was. Some vets prescribe additional medication alongside antibiotics. She is currently receiving some very strong antibiotics intravenously but again has a fever. Diagnosis of this type of pneumonia may be made tentatively if the infected dog does not respond to antibiotics since antibiotics are not effective against fungi. Good Afternoon My dog has been diagnosed with pneumonia and bortonella after having many tests coming out negative and no lymphoma.
 Source: in.pinterest.com
Source: in.pinterest.com
It is extremely important to never give your dog over-the-counter medications such as ibuprofen to reduce the fever. A fever of unknown origin may also be present. Normal temperatures in canines range from 995 to 1025 degrees F. In a dog is 102 degrees F or - 1. He isnt breaking his fever of 1038-104 even though hes been on doxycycline Zithromax for the past five days.
 Source: vetfolio.com
Source: vetfolio.com
These medications are toxic to pets and can result in serious harm or death. FUO Fever of Unknown Origin. Also at a temp of about 104 we wouldnt even use them. The second most common reason for deterioration after 72 hours is persistent or nonresponding pneumonia. Diagnosis of this type of pneumonia may be made tentatively if the infected dog does not respond to antibiotics since antibiotics are not effective against fungi.

Fever as we know it is not unique to humans dogs can also experience it and we should be alert to its warning symptoms. Fungal pneumonia may develop if the dogs inhale spores that spread through the blood and lymph systems. Also see Canine Valley Fever. Bronchodilators when there are serious breathing problems and the dog does not respond to steroids. Affected animals experience an elevated body temperature usually accompanied by lethargy weakness and lack of appetite.
 Source: pinterest.com
Source: pinterest.com
Both steroids and non-steroidal anti-inflammatory drugs are sometimes given to dogs with Lyme disease. Or the fever resolves serendipitously or in response to antibiotic therapy. Also see Canine Valley Fever. The source of most fungal infections is believed to be soil-related. Diagnosis of this type of pneumonia may be made tentatively if the infected dog does not respond to antibiotics since antibiotics are not effective against fungi.
 Source: bowwowinsurance.com.au
Source: bowwowinsurance.com.au
Up to 20 cash back No not OTC. To help reduce a pets fever103 degrees or. We have been on an antibiotic since last friday and while the fever has finally subsided she has developed a nasty cough. Also see Canine Valley Fever. Dogs that have persistent fever or a fever that waxes and wanes must undergo a thorough work-up so that the cause of fever can be discovered and treated before irreversible.
 Source: drronsanimalhospitalsimivalley.com
Source: drronsanimalhospitalsimivalley.com
Considering the antibiotics are not working I would suggest taking him back in taking a sample and run an antibiogram to determine what resistances the bacteria in question have then treat the infection accordingly. On a side note using apple cider vinegar for anything is total hogwash. When I read the side effects of the Clindamycin in particular one of them was a fever. Fever as we know it is not unique to humans dogs can also experience it and we should be alert to its warning symptoms. 1 In both dogs and humans antibiotics work by attacking and killing the bacterial infection while preventing it from growing any further.
 Source: pinterest.com
Source: pinterest.com
Of 14 dogs in which a diagnosis was. Fever of Unknown Origin in Dogs. Antibiotics if the dog has a bacterial. Regarding your dogs fever if it is definitely tick fever the doxycycline should starting working within the first 3 days or so. It is considered an emergency if your dog is extremely lethargic has blood in their stool or vomit stops eating or has a fever above 1045ºF.
 Source: pinterest.com
Source: pinterest.com
Vets even use an acronym for this. The source of most fungal infections is believed to be soil-related. Typically a physical examination and medical history lead a practitioner to a fevers cause. FUO Fever of Unknown Origin. Remember that it can not communicate what is happening or when something is wrong you must monitor its health.
 Source: bowwowinsurance.com.au
Source: bowwowinsurance.com.au
A short moist cough followed by thick mucous discharge from the nose is commonly seen. On a side note using apple cider vinegar for anything is total hogwash. There are NSAIDs that we use as fever-reducers but they are by Rx only from the vet. To help reduce a pets fever103 degrees or. Temperatures at 103ºF 394ºC or above are considered a fever.
 Source: todaysveterinarypractice.com
Source: todaysveterinarypractice.com
Temperatures that are lower or higher than usual for a dog may be an indicator of fever. Temperatures that are lower or higher than usual for a dog may be an indicator of fever. Keep in mind that normal temp. Fever can indicate infectious inflammatory immune-mediated or neoplastic disease. FUO is a condition that is common in dogs and cats according to Dr.
Source: vetfolio.com
Source: vetfolio.com
But every dog is different and depending on how severe the infection is it could take up to several weeks for. Fever refers to an abnormally high body temperature. Fever of Unknown Origin in Dogs. Up to 20 cash back She said the test for fungal infection is not available at any Vet in my area and that if I wanted to do that test I would have to cart my dog the 25 hours away again to the University of Pannsylvaniawhich I just came from 3 days ago I am heartbroken to say the least I dont think my baby will be here much longer without trying something. In a dog is 102 degrees F or - 1.
 Source: todaysveterinarypractice.com
Source: todaysveterinarypractice.com
Vets even use an acronym for this. Both steroids and non-steroidal anti-inflammatory drugs are sometimes given to dogs with Lyme disease. Sometimes history and physical exam findings can indicate the cause of the fever or source of infection. Both of these medicines are not safe for dogs so please do not administer them. Some vets prescribe additional medication alongside antibiotics.
 Source: vetfolio.com
Source: vetfolio.com
But every dog is different and depending on how severe the infection is it could take up to several weeks for. Dogs just like humans are often prescribed antibiotics to fight infections. Normal temperatures in canines range from 995 to 1025 degrees F. She is currently receiving some very strong antibiotics intravenously but again has a fever. Dog Fever Diagnosing a dog fever is difficult.
 Source: pinterest.com
Source: pinterest.com
Also at a temp of about 104 we wouldnt even use them. A fever of unknown origin may also be present. Also see Canine Valley Fever. This is because Lyme disease can cause a number of problems – including joint swelling kidney issues and fever – that need to be addressed as well. But in some cases the underlying cause of the fever is not readily apparent.
 Source: vetfolio.com
Source: vetfolio.com
The normal body temperature in dogs is between 101 and 1025º Fahrenheit 383-392º Celsius. Temperatures at 103ºF 394ºC or above are considered a fever. And there still is no diagnosis in sight. Fever refers to an abnormally high body temperature. Both steroids and non-steroidal anti-inflammatory drugs are sometimes given to dogs with Lyme disease.
 Source: keepthetailwagging.com
Source: keepthetailwagging.com
Fever of Unknown Origin in Dogs. To help reduce a pets fever103 degrees or. This is because Lyme disease can cause a number of problems – including joint swelling kidney issues and fever – that need to be addressed as well. The dog bite is MUCH better so I am pretty sure that the fever is not coming from that. FUO is a condition that is common in dogs and cats according to Dr.
 Source: todaysveterinarypractice.com
Source: todaysveterinarypractice.com
The normal body temperature in dogs is between 101 and 1025º Fahrenheit 383-392º Celsius. Or the fever resolves serendipitously or in response to antibiotic therapy. To help reduce a pets fever103 degrees or. But in some cases the underlying cause of the fever is not readily apparent. Up to 20 cash back She said the test for fungal infection is not available at any Vet in my area and that if I wanted to do that test I would have to cart my dog the 25 hours away again to the University of Pannsylvaniawhich I just came from 3 days ago I am heartbroken to say the least I dont think my baby will be here much longer without trying something.
This site is an open community for users to do submittion their favorite wallpapers on the internet, all images or pictures in this website are for personal wallpaper use only, it is stricly prohibited to use this wallpaper for commercial purposes, if you are the author and find this image is shared without your permission, please kindly raise a DMCA report to Us.
If you find this site value, please support us by sharing this posts to your favorite social media accounts like Facebook, Instagram and so on or you can also save this blog page with the title dog fever not responding to antibiotics by using Ctrl + D for devices a laptop with a Windows operating system or Command + D for laptops with an Apple operating system. If you use a smartphone, you can also use the drawer menu of the browser you are using. Whether it’s a Windows, Mac, iOS or Android operating system, you will still be able to bookmark this website.






